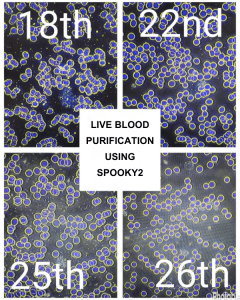

Spooky2 Central has been transforming lives with its advanced frequency healing technology, providing relief and hope to individuals facing a wide range of health challenges. From chronic conditions and acute illnesses to overall wellness enhancement, countless users have experienced remarkable improvements. This blog brings together some of the most compelling real-life success stories and valuable insights from past blogs, highlighting the profound impact of Spooky2 Central in helping people reclaim their health and well-being.
Why Users Trust Spooky2 Central
Spooky2 Central is widely praised for its exceptional power and effectiveness in frequency healing, helping users achieve rapid relief, faster recovery, and long-term wellness support.
- Fast Relief – Quickly eases discomfort and enhances mobility.
- Accelerated Recovery – Supports the body’s natural healing and energy balance.
- Long-Term Wellness – Provides deep, targeted support for sustained health.
- A Trusted Choice for Complex Health Needs – Offers non-invasive, holistic care beyond conventional methods.
If you’re seeking stronger vitality, better circulation, or a more effective wellness approach, Spooky2 Central stands out as a powerful tool for transformative healing.
Real Success Stories from Spooky2 Users
-
Blood Clot Removal
After using Spooky2 Central for two hours, a patient with blood clots in both legs was cleared for surgery, demonstrating the device’s effectiveness in addressing serious circulatory concerns.

-
Healing from a Crushed Ankle:
A diabetic man facing amputation due to a crushed ankle healed remarkably in six weeks using Spooky2 Plasma treatment, impressing his surgeons with the recovery.
-
Mental Clarity and Focus
Two nights of Spooky2 Central use improved a user’s mental clarity and energy, helping them overcome brain fog and regain focus.
-
Frequency Healing Lounge
A Frequency Healing Lounge featuring Spooky2 Central was set up in the Mid-North Coast, offering local communities access to frequency healing technology for holistic wellness.

-
Sinusitis Relief
Spooky2 Central’s Contact and Ultrasonic modes helped a user relieve sinusitis symptoms, providing immediate relief in the forehead area.
-
Blood Purification
Spooky2 Central users have reported wide-ranging benefits, from reducing pain to improving general wellness, demonstrating its versatility in supporting health.
Insights from Past Blogs: How and When to Use Spooky2 Central
Spooky2 Central has proven to be a versatile tool for supporting various health scenarios. Below are some key areas where it excels, based on insights from past blogs:
Solving Serious Health Issues
Spooky2 Central has been recognized for its ability to address serious health concerns. From circulatory health to immune function, users have reported significant improvements after incorporating the device into their healing routines. For more information on how it helps with serious health issues, read How Spooky2 Central Can Solve Serious Health Issues.
Maximizing Your Health with Spooky2 Central
Many users have found that Spooky2 Central can significantly enhance overall wellness. It supports detoxification, improves energy levels, and accelerates recovery from a variety of conditions. For more details, check out Maximize Your Health with Spooky2 Central.
Supporting Specific Health Conditions
Spooky2 Central has shown great promise in addressing specific health conditions, including breast lumps, kidney disease, and migraines.
- Using Spooky2 Central for Breast Lumps
- How to Use Spooky2 Central to Help with Kidney Disease
- How to Use Spooky2 Central to Get Rid of Migraine
- How to Use Spooky2 Central for Toothache
-
Spooky2 Central for Pets
Spooky2 Central has proven to be effective not only for human health but also for pets. Many pet owners have used Spooky2 Central to improve their pets’ well-being and support their recovery from various health issues. Learn more about its benefits for pets in Spooky2 Central: A Better Choice for Pet Health.
Testimonials Highlighting Powerful Healing Effects
Numerous testimonials showcase the profound impact Spooky2 Central has had on users, from alleviating chronic pain to supporting long-term health. For a collection of testimonials, read Spooky2 Central Testimonials: Discover its Powerful Healing Effects.
Real-Life Story: Healing from Severe Heart Issues
Spooky2 Central’s ability to support heart health has been particularly remarkable. One user shared how the device helped eliminate severe heart issues, leading to a significant improvement in their condition. Read the full story in Spooky2 Central Testimonial: It Eliminated My Heart Issues.
Conclusion
Spooky2 Central has proven to be a powerful and versatile tool in the realm of frequency healing, offering users profound benefits across a wide range of health issues. From relieving chronic pain and supporting immune function to accelerating recovery and enhancing overall wellness, its impact is undeniable. The numerous real-life success stories shared by users reflect its ability to bring rapid relief and long-term improvements, supporting both physical and mental health. Whether you’re seeking to address specific health concerns or improve your general well-being, Spooky2 Central provides a groundbreaking approach to holistic healing. With its proven effectiveness and user trust, it stands as a valuable asset for anyone looking to enhance their health and vitality.

Glad to hear some people having success. I have tried using spooky with remote for hours into days and have had zero results.
Maybe this considerably more expensive options is an option but not everyone has plenty of cash. I live on SS benefits and it’s incredibly stressful and difficult to make ends meet.
Hi RJ! I really appreciate your openness—it sounds like you’re doing your best under challenging circumstances, and that’s incredibly admirable.
Remote mode does often require more patience and consistent use, even though it works. Consider experimenting with an affordable contact accessory like Tens pads or gloves—those can sometimes bring more noticeable changes earlier.
You might also take a moment to double-check your setup: secure connections, the latest software updates, and proper run-times can all influence outcomes.
If you’d like more tailored guidance—maybe simple tips to tweak your setup or ways to stretch your budget while still exploring other modes—please feel free to ask. You’re not alone on this journey, and we genuinely want to help you make the most of what you have.
Hello! The DН Experimental frequencies (especially DH1-DH6) really helped me. I ran each program from the instructions on repeat until I got tired of it and then moved on to the next one. After a year, the effectiveness of using programs from other databases became many times more effective. I also used smoking cessation programs for my father and was able to see results only after a year. The main thing is to keep experimenting and you will definitely get results. On average, most people note a dramatic change in their well-being for the better after 2 years of using the remote mode. Also, the contact mode increases the effectiveness of treatment; it is considered that 1 hour of the contact mode corresponds to 10 hours of the remote mode, for example, 1 hour on plasma corresponds to 20 hours of the contact mode.
Thank you so much for sharing this, mozya.ya.
It’s wonderful to hear how the DH Experimental frequencies have helped you and your father over time. Your experience with the DH Experimental frequencies and the long-term improvements gives a lot of hope to people who may be struggling or unsure where to start.
Really appreciate you taking the time to write all this — personal experiences like yours are always the most helpful for others reading along.